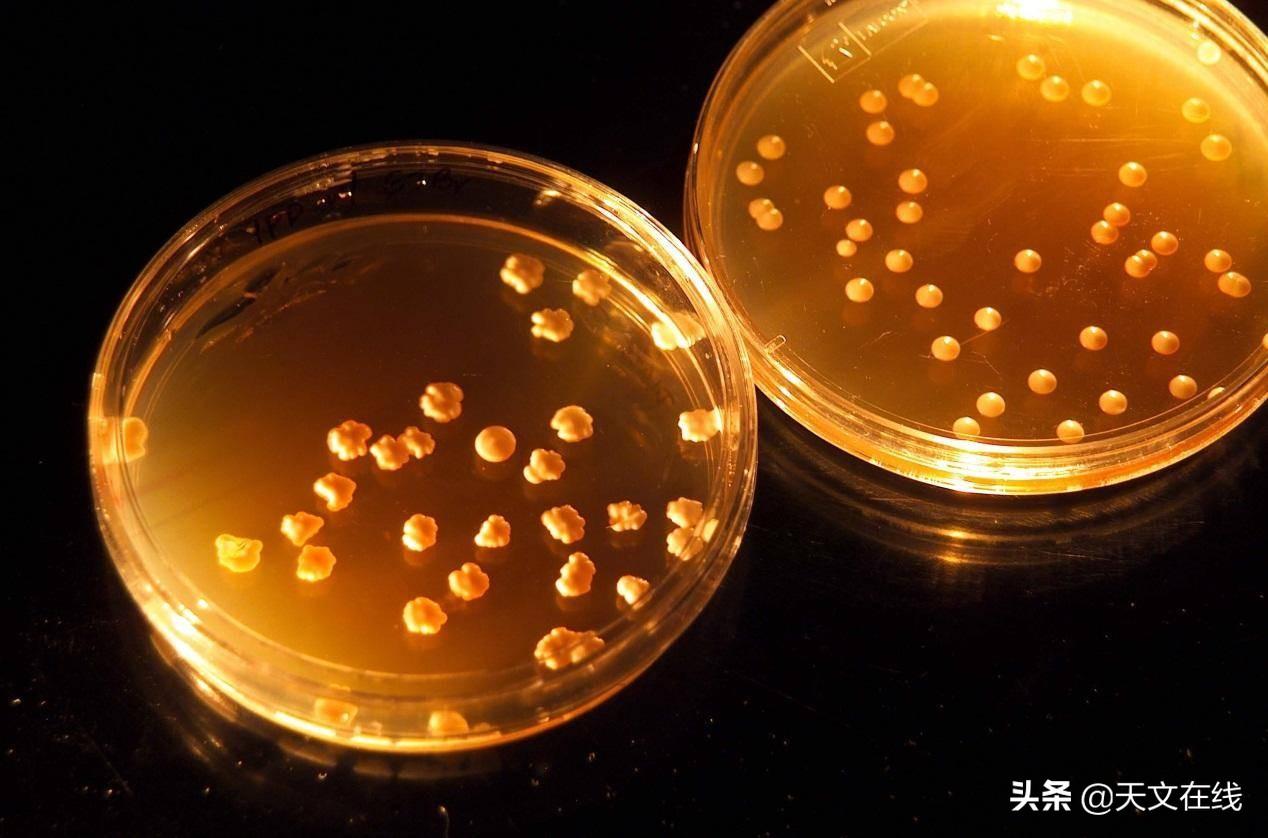

2024新奥开码结果与HBV79.680稳定版的生物学研究
引言
随着科技不断进步,生物学领域的研究不断深化,尤其是对疾病机制与疫苗开发的理解。2024年新奥开码的成果为生物医学研究提供了新的视角。同时,HBV79.680稳定版作为最新的病毒模型之一,在病毒学、免疫学等方面的研究中展现出广泛的应用潜力。本文将深入探讨2024新奥开码结果的生物学意义,以及HBV79.680稳定版在相关研究中的重要性。
新奥开码的概述
新奥开码是指一系列新技术、新发现的汇总,其结果通常为后续研究提供指导和灵感。在2024年,众多科学家通过新奥开码的方式,探索了不同生物系统及其相互作用的模式。新奥开码不仅包含了基因组学、蛋白质组学的成果,还涵盖了细胞生物学以及分子生物学的最新进展。
这几项研究的整合,不仅推动了基础生物学的进步,也促进了临床医学的发展。例如,通过对新型基因编辑技术(如CRISPR-Cas9)的应用,研究人员得以更精确地认识与治疗遗传疾病。此外,新奥开码结果还揭示了微生物组与宿主健康之间的复杂关系,为精准医疗提供了新的方向。
HBV79.680稳定版的简介
HBV79.680稳定版是指一种通过工程化手段获得的乙型肝炎病毒(HBV)模型。乙型肝炎病毒是一种致病性极强的病毒,全球有近三分之一的人口曾经感染过该病毒。在慢性HBV感染中,患者常常会发展为肝炎、肝硬化甚至肝癌。因此,深入研究HBV的生物学特性及其致病机制,对于开发有效的治疗手段至关重要。
HBV79.680稳定版的出现,标志着科学家在HBV研究中的又一重要突破。通过稳定表达的HBV模型,科学家能够在体外和体内系统中进行更有效的实验,评估各种干预手段的有效性和安全性。这不仅有助于加速疫苗的研发,还为新型抗病毒药物的发现提供了可能的筛选平台。
HBV79.680的生物学研究
1. HBV的生命周期
HBV的生命周期涉及多个复杂的步骤,包括病毒的吸附、进入、复制以及释放。在细胞内,HBV利用宿主细胞的机制进行自我复制。HBV79.680稳定版通过模拟这一过程,帮助研究人员更准确地解析HBV的生物学特性。
在这个模型中,研究人员可以观察到病毒如何与宿主细胞膜结合、如何进入细胞以及在细胞内如何进行转录和翻译。这些研究结果为理解HBV的致病机制打下了基础。
2. 免疫应答与病毒逃逸机制
HBV感染后,宿主的免疫系统会启动一系列反应以控制病毒。然而,HBV通过多种机制逃避宿主免疫系统的攻击。例如,HBV能够抑制干扰素的产生,降低抗病毒T细胞的活性。HBV79.680稳定版使得研究人员能够评估不同免疫应答的效果,以及HBV如何调节这些应答。
在相关实验中,HBV79.680的应用使得科学家能够识别病毒抗原与宿主免疫细胞的相互作用,帮助开发新的免疫疗法,提高宿主对病毒的抵抗力。
3. 毒性及转化能力的研究
HBV的某些变异株与肝癌的发展密切相关。HBV79.680稳定版的建立,使得科学家能够研究不同HBV株在实验条件下的毒性和转化能力。这项研究的结果不仅有助于阐明HBV与肝癌的关联,也为早期肺癌的生物标志物的开发铺平了道路。
新奥开码结果与HBV79.680稳定版的关联
新奥开码的各项成果为HBV79.680模型的应用提供了坚实的基础。例如,基因组学的进展使得科学家能够对HBV进行精确的遗传密码解析,从而识别与病理过程相关的特定基因。此外,蛋白质组学的应用使得研究人员可以全面了解HBV的蛋白质表达及其功能,为寻找新的药物靶点提供了切实可行的方向。
未来研究的展望
未来,HBV79.680稳定版和新奥开码的结合将推动更深入的生物学研究。有望开发出更有效的HBV疫苗和抗病毒药物,以减轻全球健康负担。同时,借助新奥开码的技术,科学家将能够更好地理解病毒与宿主细胞之间的相互作用,为抗病毒研究开辟新颖的路径。
1. 药物研发
基于HBV79.680稳定版的细胞模型,新兴的药物开发将更加迅速。借助高通量筛选技术,研究人员可以在短时间内筛选出多种新药物,并评估其抗病毒效果。这种方法将大大加速抗HBV药物的发现与开发。
2. 精准医疗
结合新奥开码的结果,未来的HBV研究可以实现精准医疗的发展。通过对患者个体基因组及病毒变异的分析,研究者可以制定个性化的治疗方案,使得治疗效果最大化,副作用最小化。
结论
2024新奥开码结果在生物学领域的突破为HBV79.680稳定版的研究打下了坚实的基础。HBV79.680稳定版在病毒治疗、免疫应答及疾病机理研究中的应用,展现了其在未来生物医学研究中的重要性。结合新奥开码的成果,科学家们有望在乙型肝炎及其相关疾病的治疗上取得更大的进展,为公共健康贡献新的力量。随着研究的深入,期待未来能不再有乙型肝炎对人类健康的威胁。

京公网安备11000000000001号
京ICP备11000001号